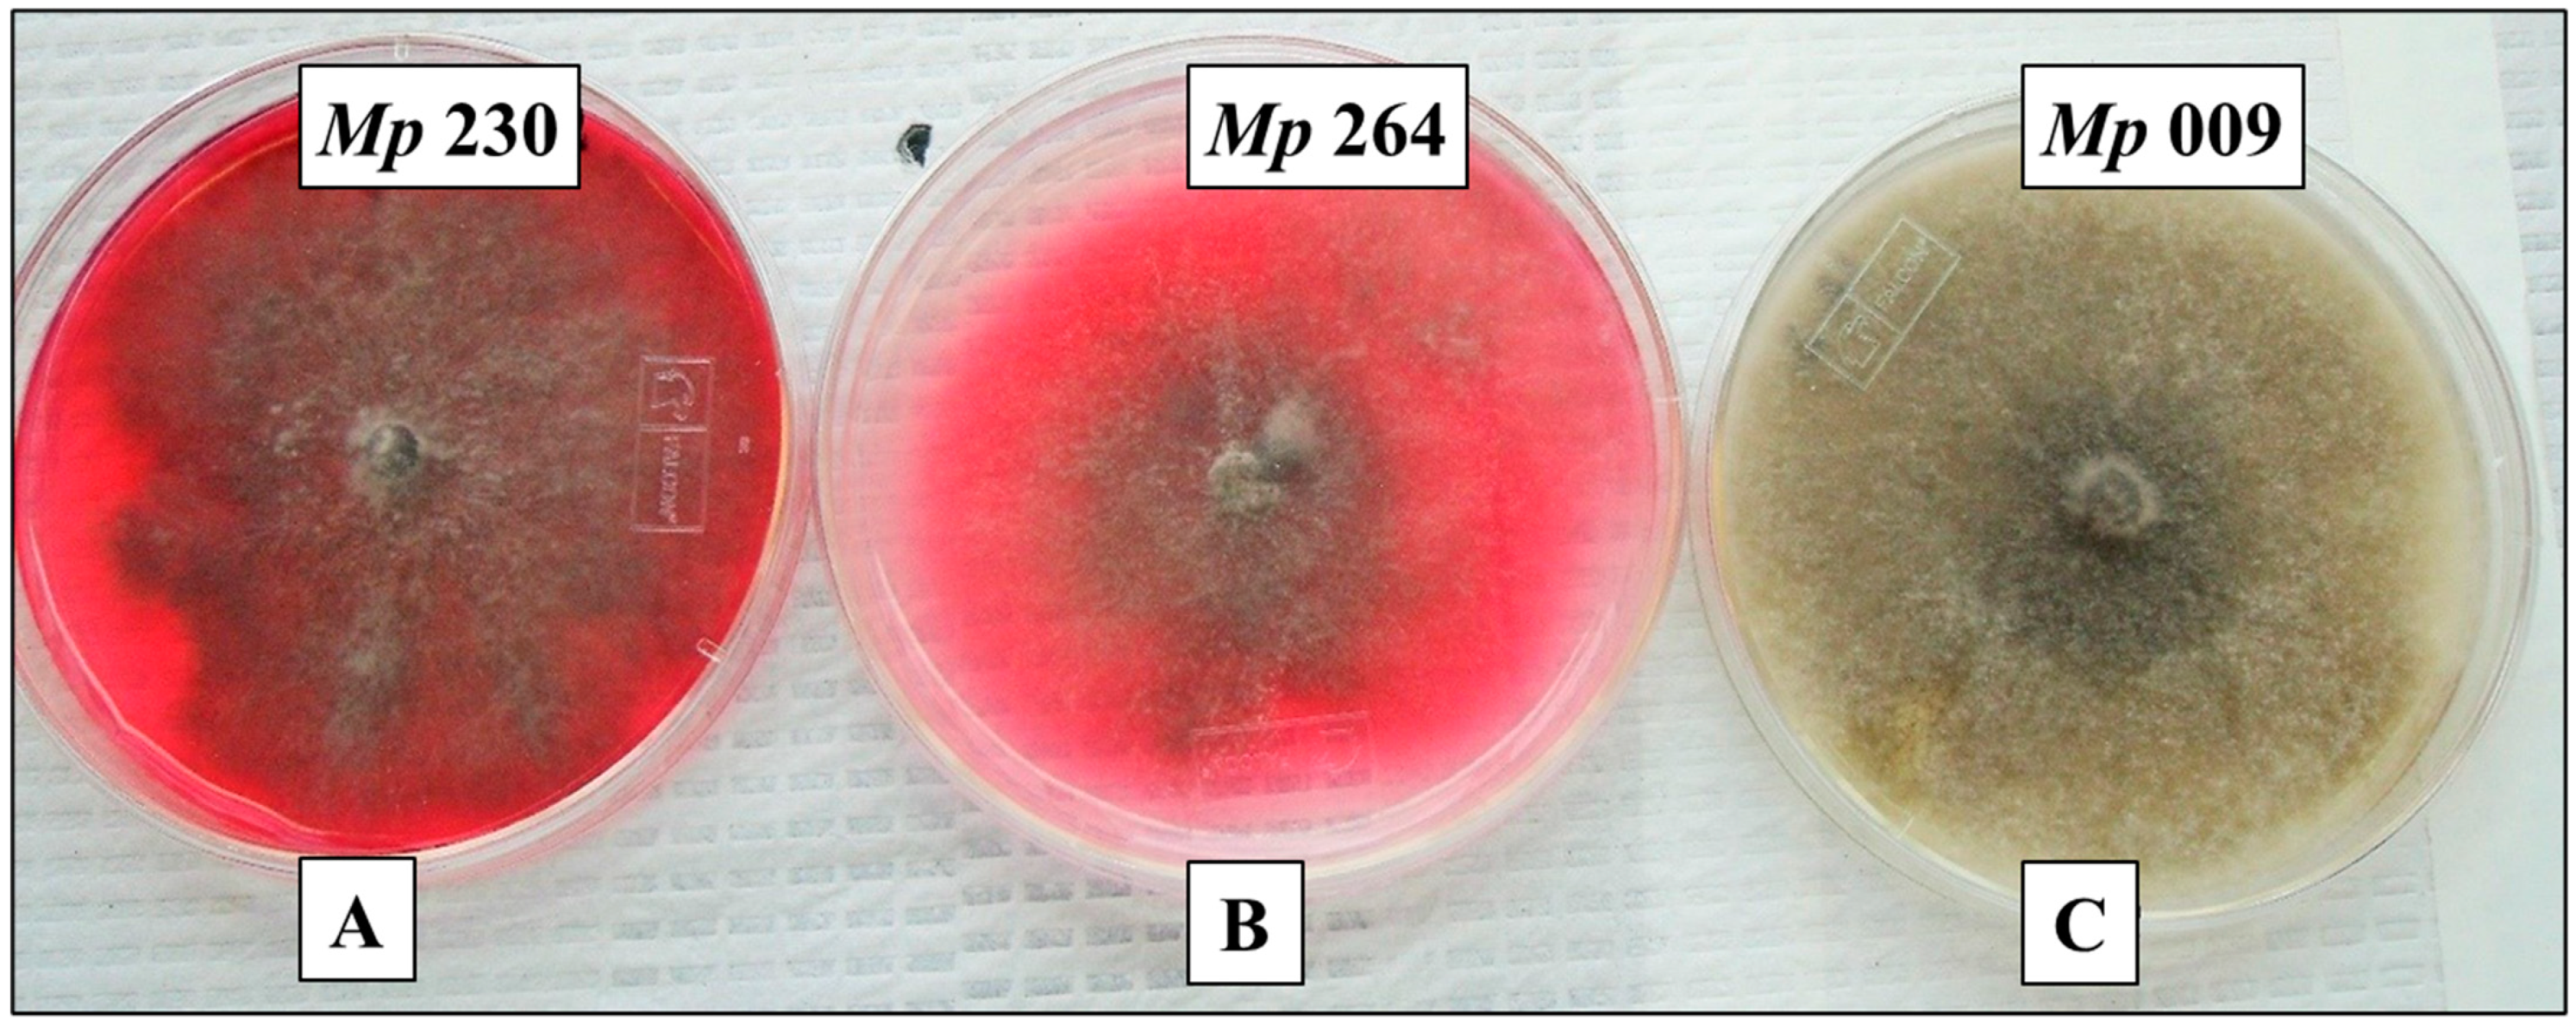

Pigment Produced by Glycine-Stimulated Macrophomina Phaseolina Is a (−)-Botryodiplodin Reaction Product and the Basis for an In-Culture Assay for (−)-Botryodiplodin Production
Abstract
:1. Introduction
2. Results
2.1. Selection of M. phaseolina Isolates for Detailed Study
2.2. Optimum Glycine Concentration for Pigment Production
2.3. Time Course for Pigment Production by Selected Isolates
2.4. Effect of Czapek-Dox Medium Components on Pigment Production by Selected Isolates of M. phaseolina
2.5. Pigment Production by Reaction of (±)-Botryodiplodin with Glycine and Other Amines
2.6. Mycotoxin Production by the Selected Isolates of M. phaseolina
2.7. Time Course for (−)-Botryodiplodin Production by Selected Isolates
2.8. Absorption Spectra of Pigments Produced by Selected M. phaseolina Isolates and Pigments Formed by Reaction with (±)-Botryodiplodin in Czapek-Dox Agar Medium with Glycine
2.9. Pigment Production on Glycine-Supplemented Medium As an In-Culture Method for Demonstrating (−)-Botryodiplodin Producing Ability by Pathogenic Isolates of M. phaseolina
3. Discussion
4. Conclusions
5. Materials and Methods
5.1. Materials
5.2. Fungal Strains, Media and Culture Conditions
5.3. Extraction and Assay of (−)-Botryodiplodin and Pigment Produced on Agar Medium by Selected M. phaseolina Isolates
5.4. (−)-Botryodiplodin Production by Selected M. phaseolina Isolates on Liquid Medium
5.5. Glycine Concentration for Optimal Pigment Production
5.6. Time Courses of Pigment and (−)-Botryodiplodin Production by Selected M. phaseolina Isolates
5.7. Stimulation of Pigment Production by Culture Medium Components
5.8. Pigment Formation by Reaction of (±)-Botryodiplodin with Amines in Solution
5.9. UV-Vis Absorption Spectra of Pigments Formed in Agar Medium
5.10. Statistical Analysis
Author Contributions
Funding
Data Availability Statement
Conflicts of Interest
References
- Schmidt, O. Wood and Tree Fungi; Springer: Berlin/Heidelberg, Germany, 2006; p. 125. ISBN 3-540-32138-1. [Google Scholar]
- Dunlap, J.R.; Bruton, D.B. Pigment biosynthesis by Macrophomina phaseolina: The glycine-specific requirement. Trans. Br. Mycol. Soc. 1986, 86, 111–115. [Google Scholar] [CrossRef]
- Dhingra, O.D.; Sinclair, J.B. Location of Macrophomina phaseolina on soybean plants related to culture characteristics and virulence. Phytopathology 1973, 63, 934–936. [Google Scholar] [CrossRef]
- Ghosh, T.; Biswas, M.K.; Guin, C.; Roy, P. A review on characterization, therapeutic approaches and pathogenesis of Macrophomina phaseolina. Plant Cell Biotechnol. Mol. Biol. 2018, 19, 72–84. [Google Scholar]
- Mengistu, A.; Ray, J.D.; Smith, J.R.; Paris, R.L. Charcoal rot disease assessment of soybean genotypes using a colony-forming unit index. Crop Sci. 2007, 47, 2453–2461. [Google Scholar] [CrossRef]
- Wyllie, T.D. Macrophomina phaseolina—Charcoal rot. In World Soybean Research: Proceedings of the World Soybean Research Conference; Hill, L.D., Ed.; Interstate Printers and Publishers Inc.: Danville, IL, USA, 1976; pp. 482–484. [Google Scholar]
- Bellaloui, N.; Mengistu, A.; Smith, J.R.; Abbas, H.K.; Accinelli, C.; Shier, W.T. Effects of charcoal rot on soybean seed composition in soybean genotypes that differ in charcoal rot resistance under irrigated and non-irrigated conditions. Plants 2021, 10, 1801. [Google Scholar] [CrossRef] [PubMed]
- Bellaloui, N.; Mengistu, A.; Zobiole, L.H.S.; Shier, W.T. Resistance to toxin-mediated fungal infection: Role of lignins, isoflavones, other seed phenolics, sugars, and boron in the mechanism of resistance to charcoal rot disease in soybean. Toxin Rev. 2012, 31, 16–26. [Google Scholar] [CrossRef]
- Bowen, C.R.; Schapaugh, W.T. Relationships among charcoal rot infection, yield, and stability estimates in soybean blends. Crop. Sci. 1989, 29, 42–46. [Google Scholar] [CrossRef]
- Gupta, G.K.; Sharma, S.K.; Ramteke, R. Biology, epidemiology and management of the pathogenic fungus Macrophomina phaseolina (Tassi) Goid with special reference to charcoal rot of soybean (Glycine max (L.) Merrill). J. Phytopathol. 2012, 160, 167–180. [Google Scholar] [CrossRef]
- Wrather, J.A.; Stienstra, W.C.; Koenning, S.R. Soybean disease loss estimates for the United States from 1996 to 1998. Can. J. Plant Pathol. 2001, 23, 122–131. [Google Scholar] [CrossRef]
- Wrather, J.A.; Koenning, S.R.; Anderson, T.R. Effect of diseases on soybean yields in the United States and Ontario (1999–2002). Plant Health Prog. 2003, 4, 24. [Google Scholar] [CrossRef] [Green Version]
- Wrather, J.A.; Koenning, S.R. Estimates of disease effects on soybean yields in the United States 2003 to 2005. J. Nematol. 2006, 38, 173–180. [Google Scholar]
- Mengistu, A.; Reddy, K.N.; Zablotowicz, R.M.; Wrather, A.J. Propagule densities of Macrophomina phaseolina in soybean tissue and soil as affected by tillage, cover crop, and herbicides. Plant Health Prog. 2009, 10, 28. [Google Scholar] [CrossRef] [Green Version]
- Mengistu, A.; Wrather, A.; Rupe, J.C. Charcoal rot. In Compendium of Soybean Diseases and Pests, 5th ed.; Hartman, G.L., Rupe, J.C., Sikora, E.J., Domier, L.L., Davis, J.A., Steffey, K.L., Eds.; American Phytopathology Society: St. Paul, MN, USA, 2015; pp. 67–69. [Google Scholar]
- Mihail, J.D. Macrophomina. In Methods for Research on Soilborne Phytopathogenic Fungi; Singleton, L., Mihail, J.D., Rush, C.M., Eds.; APS Press, The American Phytopathological Society: St. Paul, MN, USA, 1992; pp. 134–136. [Google Scholar]
- Medhaug, I.; Stolpe, M.B.; Fischer, E.M.; Knutti, R. Reconciling controversies about the ‘global warming hiatus’. Nature 2017, 545, 41–47. [Google Scholar] [CrossRef] [PubMed]
- Khambhati, V.H.; Abbas, H.K.; Sulyok, M.; Tomaso-Peterson, M.; Shier, W.T. First report of the production of mycotoxins and other secondary metabolites by Macrophomina phaseolina (Tassi) Goid. isolates from soybeans (Glycine max L.) symptomatic with charcoal rot disease. J. Fungi 2020, 6, 332. [Google Scholar] [CrossRef]
- Dhar, T.K.; Siddiqui, K.A.I.; Ali, E. Structure of phaseolinone, a novel phytotoxin from Macrophomina phaseolina. Tetrahedron Lett. 1982, 23, 5459–5462. [Google Scholar]
- Mahato, S.B.; Siddiqui, K.A.I.; Bhattacharya, G.; Ghosal, T.; Miyahara, K.; Sholichin, M.; Kawasaki, T. Structure and stereochemistry of phaseolinic acid: A new acid from Macrophomina phaseolina. J. Nat. Prod. 1987, 50, 245–247. [Google Scholar] [CrossRef]
- Ramezani, M.; Shier, W.T.; Abbas, H.K.; Tonos, J.L.; Baird, R.E.; Sciumbato, G.L. Soybean charcoal rot disease fungus Macrophomina phaseolina in Mississippi produces the phytotoxin (−)-botryodiplodin but no detectable phaseolinone. J. Nat. Prod. 2007, 70, 128–129. [Google Scholar] [CrossRef] [PubMed]
- Bhattacharya, D.; Dhar, T.K.; Ali, E. An enzyme immunoassay of phaseolinone and its application in estimation of the amount of toxin in Macrophomina phaseolina-infected seeds. Appl. Environ. Microbiol. 1992, 58, 1970–1974. [Google Scholar] [CrossRef] [PubMed] [Green Version]
- Masi, M.; Sautua, F.; Zatout, R.; Castaldi, S.; Arrico, L.; Isticato, R.; Pescitelli, G.; Carmona, M.A.; Evidente, A. Phaseocyclopentenones A and B, phytotoxic penta- and tetrasubstituted cyclopentenones produced by Macrophomina phaseolina, the causal agent of charcoal rot of soybean in Argentina. J. Nat. Prod. 2021, 84, 459–465. [Google Scholar] [CrossRef] [PubMed]
- Abbas, H.; Bellaloui, N.; Accinelli, C.; Smith, J.R.; Shier, W.T. Toxin production in soybean (Glycine max L.) plants with charcoal rot disease and by Macrophomina phaseolina, the fungus that causes the disease. Toxins 2019, 11, 645. [Google Scholar] [CrossRef] [Green Version]
- Sen Gupta, R.; Chandran, R.R.; Divekar, P.V. Botryodiplodin, a new antibiotic from Botryodiplodia theobromae Part. I. Production, isolation and biological properties. Indian J. Exp. Biol. 1966, 4, 152–153. [Google Scholar]
- Cabedo, N.; Lopez-Gresa, M.P.; Primo, J.; Ciavatta, M.L.; Gonzalez-Mas, M.C. Isolation and structural elucidation of eight new related analogues of the mycotoxin (−)-botryodiplodin from Penicillium coalescens. J. Agric. Food Chem. 2007, 55, 6977–6983. [Google Scholar] [CrossRef] [PubMed] [Green Version]
- Renauld, F.; Moreau, S.; Lablachecombier, A.; Tiffon, B. Botryodiplodin, a mycotoxin from Penicillium roqueforti. Reaction with amino-pyrimidines, amino-purines and 2-deoxynucleosides. Tetrahedron 1985, 41, 955–962. [Google Scholar] [CrossRef]
- Nielsen, K.F.; Sumarah, M.W.; Frisvad, J.C.; Miller, J.D. Production of metabolites from the Penicillium roqueforti complex. J. Agric. Food Chem. 2006, 54, 3756–3763. [Google Scholar] [CrossRef]
- Fuska, J.; Kuhr, I.; Nemec, P.; Fuskova, A. Antitumor antibiotics produced by Penicillium stipitatum Thom. J. Antibiot. 1974, 27, 123–127. [Google Scholar] [CrossRef] [Green Version]
- Nakagawa, F.; Kodama, K.; Furuya, K.; Naito, A. New strains of botryodiplodin producing fungi. Agric. Biol. Chem. 1979, 43, 1597–1598. [Google Scholar] [CrossRef]
- Bladt, T.T.; Frisvad, J.C.; Knudsen, P.B.; Larsen, T.O. Anticancer and antifungal compounds from Aspergillus, Penicillium and other filamentous fungi. Molecules 2013, 18, 11338–11376. [Google Scholar] [CrossRef] [Green Version]
- McCurry, P.M.; Abe, K. Stereochemistry and synthesis of the antileukemic agent botryodiplodin. J. Am. Chem. Soc. 1973, 95, 5824–5825. [Google Scholar] [CrossRef] [PubMed]
- Moule, Y.; Decloitre, F.; Hamon, G. Mutagenicity of the mycotoxin botryodiplodin in the Salmonella typhimurium/ microsomal activation test. Environ. Mutagenesis 1981, 3, 287–291. [Google Scholar] [CrossRef] [PubMed]
- Shier, W.T.; Nelson, J.; Abbas, H.K.; Baird, R.E. Root toxicity of the mycotoxin botryodiplodin in soybean seedlings. Toxicon 2012, 60, 163. [Google Scholar] [CrossRef]
- Moule, Y.; Douce, C.; Moreau, S.; Darracq, N. Effects of the mycotoxin botryodiplodin on mammalian cells in culture. Chem.-Biol. Interact. 1981, 37, 155–164. [Google Scholar] [CrossRef]
- Moule, Y.; Darracq, N. Absence of DNA breaks during repair of DNA-protein cross-links induced by the mycotoxin botryodiplodin in mammalian cells. Carcinogenesis 1984, 5, 1375–1377. [Google Scholar] [CrossRef] [PubMed]
- Gupta, A.; Gopal, M. Aflatoxin production by Aspergillus flavus isolates pathogenic to coconut insect pests. World J. Microbiol. Biotechnol. 2002, 18, 329–335. [Google Scholar] [CrossRef]
- Abbas, H.K.; Shier, W.; Horn, B.; Weaver, M. Cultural methods for aflatoxin detection. J. Toxicol. Toxin Rev. 2004, 23, 295–315. [Google Scholar] [CrossRef]
- Shier, W.T.; Abbas, H.K.; Baird, R.E.; Ramezani, M.; Sciumbato, G.L. (−)-Botryodiplodin, a unique ribose-analog toxin. Toxin Rev. 2007, 26, 343–386. [Google Scholar] [CrossRef]
- Abbas, H.; Bellaloui, N.; Butler, A.; Nelson, J.; Abou-Karam, M.; Shier, W.T. Phytotoxic responses of soybean (Glycine max L.) to botryodiplodin, a toxin produced by the charcoal rot disease fungus, Macrophomina phaseolina. Toxins 2020, 12, 25. [Google Scholar] [CrossRef] [Green Version]
- Lin, M.T.; Dianese, J.C. A coconut-agar medium for rapid detection of aflatoxin production by Aspergillus spp. Phytopathology 1976, 66, 1466–1499. [Google Scholar] [CrossRef]
- Saito, M.; Machida, S. A rapid identification method for aflatoxin-producing strains of Aspergillus flavus and A. parasiticus by ammonia vapor. Mycoscience 1999, 40, 205–208. [Google Scholar] [CrossRef]
- Abbas, H.K.; Weaver, M.A.; Horn, B.W.; Carbone, I.; Monacell, J.T.; Shier, W.T. Selection of Aspergillus flavus isolates for biological control of aflatoxins in corn. Toxin Rev. 2011, 30, 59–70. [Google Scholar] [CrossRef]
- Fente, C.A.; Jaimez Ordaz, J.; Vázquez, B.I.; Franco, C.M.; Cepeda, A. New additive for culture media for rapid identification of aflatoxin-producing Aspergillus strains. Appl. Environ. Microbiol. 2001, 67, 4858–4862. [Google Scholar] [CrossRef] [PubMed] [Green Version]
- Shier, W.T.; Lao, Y.; Steele, T.W.J.; Abbas, H.K. Yellow pigments used in rapid identification of aflatoxin-producing Aspergillus strains are anthraquinones associated with the aflatoxin biosynthetic pathway. Bioorganic Chem. 2005, 33, 426–438. [Google Scholar] [CrossRef] [PubMed]
- Mengistu, A.; Smith, J.R.; Ray, J.D.; Bellaloui, N. Seasonal progress of charcoal rot and its impact on soybean productivity. Plant Dis. 2011, 95, 1159–1166. [Google Scholar] [CrossRef] [PubMed] [Green Version]
- Sulyok, M.; Stadler, D.; Steiner, D.; Krska, R. Validation of an LC-MS/MS-based dilute-and-shoot approach for the quantification of >500 mycotoxins and other secondary metabolites in food crops: Challenges and solutions. Anal. Bioanal. Chem. 2020, 412, 2607–2620. [Google Scholar] [CrossRef] [PubMed] [Green Version]
- SANTE/12089/2016; Guidance Document on Identification of Mycotoxins in Food and Feed. European Commission Directorate General for Health and Food Safety: Brussels, Belgium, 2016. Available online: https://ec.europa.eu/food/sites/food/files/safety/docs/cs_contaminants_sampling_guid-doc-ident-mycotoxins.pdf (accessed on 11 January 2021).

| M. phaseolina Metabolite (mg/L) | M. phaseolina 230 | M. phaseolina 183 | M. phaseolina 312 | M. phaseolina 264 | M. phaseolina 009 | M. phaseolina 239 |
|---|---|---|---|---|---|---|
| (−)-Botryodiplodin | 34.0 | 64.7 | 56.6 | 44.0 | 0.0 | 0.0 |
| Moniliformin | 0.006 | 0.045 | 0.031 | 0.007 | 0.082 | 0.0 |
| Kojic acid | 0.142 | 0.044 | 0.109 | 0.102 | 0.0 | 0.0 |
| Orsellinic acid | 2.86 | 1.90 | 1.86 | 0.722 | 0.0 | 0.563 |
| Cordycepin | 0.0 | 0.0 | 0.0 | 0.0 | 0.001 | 0.002 |
| cyclo(L-Pro-L-Tyr) | 0.0 | 0.0 | 0.0 | 0.0 | 0.095 | 0.022 |
| cyclo(L-Pro-L-Val) | 0.0 | 0.0 | 0.0 | 0.0 | 0.134 | 0.067 |
| Gliocladic acid | 0.0 | 0.018 | 0.0 | 0.0 | 0.0 | 0.0 |
| Dihydrocitrinone | 0.0 | 0.0 | 0.0 | 0.0 | 0.001 | 0.0 |
Publisher’s Note: MDPI stays neutral with regard to jurisdictional claims in published maps and institutional affiliations. |
© 2022 by the authors. Licensee MDPI, Basel, Switzerland. This article is an open access article distributed under the terms and conditions of the Creative Commons Attribution (CC BY) license (https://creativecommons.org/licenses/by/4.0/).
Share and Cite
Alam, S.; Abbas, H.K.; Sulyok, M.; Khambhati, V.H.; Okunowo, W.O.; Shier, W.T. Pigment Produced by Glycine-Stimulated Macrophomina Phaseolina Is a (−)-Botryodiplodin Reaction Product and the Basis for an In-Culture Assay for (−)-Botryodiplodin Production. Pathogens 2022, 11, 280. https://doi.org/10.3390/pathogens11030280
Alam S, Abbas HK, Sulyok M, Khambhati VH, Okunowo WO, Shier WT. Pigment Produced by Glycine-Stimulated Macrophomina Phaseolina Is a (−)-Botryodiplodin Reaction Product and the Basis for an In-Culture Assay for (−)-Botryodiplodin Production. Pathogens. 2022; 11(3):280. https://doi.org/10.3390/pathogens11030280
Chicago/Turabian StyleAlam, Sahib, Hamed K. Abbas, Michael Sulyok, Vivek H. Khambhati, Wahab O. Okunowo, and Wayne Thomas Shier. 2022. "Pigment Produced by Glycine-Stimulated Macrophomina Phaseolina Is a (−)-Botryodiplodin Reaction Product and the Basis for an In-Culture Assay for (−)-Botryodiplodin Production" Pathogens 11, no. 3: 280. https://doi.org/10.3390/pathogens11030280
APA StyleAlam, S., Abbas, H. K., Sulyok, M., Khambhati, V. H., Okunowo, W. O., & Shier, W. T. (2022). Pigment Produced by Glycine-Stimulated Macrophomina Phaseolina Is a (−)-Botryodiplodin Reaction Product and the Basis for an In-Culture Assay for (−)-Botryodiplodin Production. Pathogens, 11(3), 280. https://doi.org/10.3390/pathogens11030280








